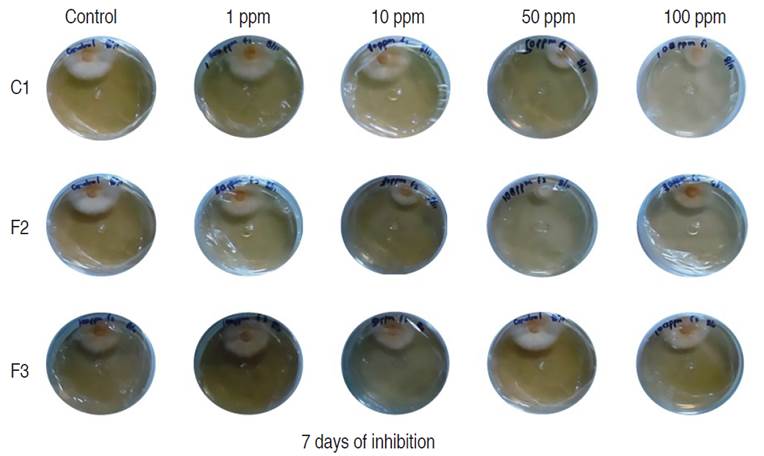
Inhibition of mycelial growth of M. roreri in PDA media with different compounds (C1, F2 and F3) evaluated 7 days after inoculation.

Artículos
Bioactive compounds against Moniliophthora roreri (Cif & Par) identified in locally produced liquid amendments (biols)
Compuestos bioactivos contra Moniliophthora roreri (Cif & Par) identificados en enmiendas líquidas producidas localmente (bioles)
Bioactive compounds against Moniliophthora roreri (Cif & Par) identified in locally produced liquid amendments (biols)
Revista Facultad Nacional de Agronomía Medellín, vol. 76, no. 2, pp. 10323-10333, 2023
Facultad de Ciencias Agrarias - Universidad Nacional de Colombia
Received: 18 June 2022
Accepted: 06 August 2022
ABSTRACT: The use of liquid organic amendments (biols) is a common practice for farmers due to the multiple benefits in the management and production of their crops, including the control of pests and diseases. The present study analyzes the chemical composition of the pure compound C1 and fractions F2 and F3 of local biols produced in two provinces of Ecuador and their antifungal activity against Moniliophthora roreri (Cif & Par). This work incorporates the use of Gas Chromatography coupled to Mass Spectrometry (GC-MS), Nuclear Magnetic Resonance (NMR) and in vitro inhibition assays for sample analysis. C1 was identified as Mannitol. The percentage of inhibition against M. roreri in F2 and F3 was 44.37% and 8.34%, respectively; and, for C1, 28.63%. The values of the median lethal dose (LD50) obtained corroborate that the F2 fraction was the one with the highest controlling activity against the pathogen. The 1,2-benzenedicarboxylic acid diisooctyl ester compound was the main compound in F2 (30.88%) and the Pentadecanoic acid, 14-methyl-, methyl ester in F3. Finally, all compounds obtained from the biol fractions were identified and it was determined that the fermentative process was suitable for producing bioactive compounds of interest to inhibit the growth of Moniliophthora roreri.
Keywords: Agriculture, Biopreparations, Fermentative process, Phytopathogens, Plaguicide.
RESUMEN: El uso de enmiendas orgánicas líquidas (bioles) es una práctica común para los agricultores por los múltiples beneficios en el manejo y producción de sus cultivos, incluyendo el control de plagas y enfermedades. El presente estudio analiza la composición química del compuesto puro C1 y fracciones F2 y F3 de bioles locales producidos en dos provincias del Ecuador y su actividad antifúngica frente a Moniliophthora roreri (Cif & Par). Este trabajo incorpora el uso de Cromatografía de Gases acoplado a Espectrometría de Masas (CG-EM), Resonancia Magnética Nuclear (RMN) y ensayos de inhibición in vitro para el análisis de las muestras. C1 fue identificado como Manitol. El porcentaje de inhibición contra M. roreri en F2 y F3 fue del 44,37% y 8,34% respectivamente; y de C1, 28,63 %. Los valores de las dosis letales media (DL50) obtenidos corroboraron que la fracción F2 fue la que mayor actividad controladora tuvo frente al patógeno. Los compuestos éster diisooctil del ácido 1,2-bencenicarboxílico fue el compuesto mayoritario en F2 (30,88%) y el ácido pentadecanoico, 14-metil-, éster metílico en F3. Finalmente, se identificaron todos los compuestos de las fracciones obtenidas a partir de biol, y se determinó que el proceso fermentativo era adecuado para producir compuestos bioactivos de interés para inhibir el crecimiento de Moniliophthora roreri.
Palabras clave: Agricultura, Biopreparados, Proceso fermentativo, Fitopatógenos, Plaguicidas.
Organic amendments have become one of the widely used cultural strategies for disease control (Hidalgo et al. 2009; Jaramillo-Rodríguez 2015; Troncoso et al. 2015; Goyes-Campos and Monserrate-Gómez 2017; Varo-Suárez 2017) and improved crop productivity, properties attributed to the presence of micronutrients (León-Aguilar et al. 2016) and other components such as humic acids, phytohormones, enzymes, and efficient microorganisms (Quiroga et al. 2013; Troncoso et al. 2015; Serrano 2017). Besides, to incrase production, the application of organic amendments increases the values of ascorbic acid, beta-carotene, and chemical compounds in plants with high added value for human health.
The efficacy of these biopreparations in the control of plant pathogens has also been evaluated in field experiments suggesting the presence of antifungal compounds. Earlier work shows the use of organic amendments controlling important pathogens such as Phytophthora capcisi and Fusarium spp, affecting chile plants, and carnation (Uribe-Lorio et al. 2014), asparagus, and tomato crops, respectively (Melero-Vara et al. 2017). The positive effect of using organic amendments has also been documented for nematode control, including Meloidogyne incognita, a nematode affecting bell pepper (Revilla-Cervantes and Palomo-Herrera 2016), and some other species affecting tomatoes (Bernal 2010).
Cacao is one of the main crops cultivated in Ecuador. However, plantations continue to be severely affected by diseases, including Frosty Pod Rot or Moniliasis, caused by Moniliophthora roreri Cif & Par (Anzules-Toala 2021). Enríquez (2010) reports that the disease with the highest incidence in cacao cultivars in Ecuador and Colombia is Moniliasis, with an average production loss from 20% to 30%. The use of fungicides helps to fight infection. However, there are risks of contamination to farmers and the environment. Additionally, their high cost is a burden for the majority of small-scale farmers who cultivate cacao in the country. One of the alternatives for the control of this pathogen is the use of fermented products using manure and several other products referred to as biopreparations. Previous work showed that bioles could have fungistatic activity against the mycelial growth of M. roreri in vitro conditions (Magdama-Tobar 2016).
The composition of bioles, macro and micronutrients, the chemical identification of phytohormones, and the quantification of saponins and alkaloids have also been assessed (Jiménez 2008; Manzano et al. 2010). Several efforts have been carried out to standardize the production of bioles, as their elaboration process can be a significant variable, using quality indicators that included physical-chemical parameters (Orellana et al. 2013). Despite all the above mentioned, still there is lacking information about the active molecules or compounds present in these types of liquid amendments.
The present study aims to determine the chemical composition of bioles, assessing the activity of some fractions and pure compounds obtained by chromatographic and spectroscopic methods. The results presented in this study are of great significance for agriculture as the bioactive molecules identify in these types of products, can reinforce their use for the management of complex diseases affecting crops and food security.
MATERIALS AND METHODS
The samples processed included 10 g of lyophilized bioles elaborated at the provinces of El Oro (F2) and Guayas (F3) following anaerobic fermentation. These bioles were formulated based on internal CIBE (Biotechnological Research Center of Ecuador) protocols, containing manure, molasses, local microorganisms, and several minerals, as their main components. Further, samples were dehydrated at 60 °C in an oven with an air circulation system and subjected to constant reflux exposure to hexane, used as the main solvent, for 2 h. The hexane residues, namely F2 and F3, were later homogenized separately in a mortar with 25 g of silica without plaster with a particle size of 20-60 mesh to form a chromatography column head of 80 cm in length and 5 cm in diameter. It includes a 45 µm porous Teflon frit which was packed with 300 g of silica of 60-200 mesh. Fractioning was carried out with a mixture of solvents including, 100% ethyl acetate, ethyl acetate/methanol (80:20), and ethyl acetate/methanol (60:40). The latter was chosen for chemical characterization and antifungal evaluation against M. roreri. Qualitative analysis by thin-layer chromatography (TLC) was also performed on 60 F254 silica gel chromatoplate (Merck) and observed under UV light of 254 nm.
The ethyl acetate/methanol fractions (60:40) obtained from each of the bioles were rotovaporated to be reconstituted and analyzed by GC-MS, using an Agilent 7890A gas chromatograph with Agilent 5975 detector (Avondale, PA.USA), equipped with an HP 5MS column of 25 m length (0.25 mm diameter and 0.25 µm film thickness). The weight of each sample used for this process was: F2 (721 mg) and F3 (800 mg). Analytical grade helium was used as the carrier gas, and the analysis conditions were as follows: initial oven temperature: 100 °C for 3 min, increasing 8 °C min-1 to a final temperature of 250 °C, maintaining for 10 min. Injector and mass detector temperature: 250 °C and 300 °C, respectively. The mass detector was operated at 70 eV in scan mode with a range of 100 to 400 mass units. Assignment of F2 and F3 GC-MS structures was carried out by comparing the mass spectra of the compounds with those of the team libraries: Wiley, the 9th edition, and NIST- 2011 (Chóez-Guaranda et al. 2022).
The pure compound (C1), also obtained with ethyl acetate/methanol (60:40), was characterized by determining its melting point and analysis of the 1H NMR spectra (399 MHz), 13C NMR (100 MHz), and DMSO as a solvent in a VARIAN-400MHz NMR spectrometer. Chemical shifts (δ) were expressed in parts per million. The values of the coupling constants (J) are expressed in Hertz, the spectrometer temperature was 25 °C, the spin of 20 Hz for 1H, 13C for the rest of the experiments, and the spin goes off.
Inhibition tests against M. roreri strains of the pure compound and sub-fractions obtained: C1, F2, and F3, were carried out by the agar diffusion method (Montes-de-Oca-Marquez et al. 2017). The strain used in this study was obtained from a cacao infected pod showing symptoms of Frosty Pod Rot. The identity of the fungus isolated was corroborated by partial sequencing of the ITS region of the ribosomal DNA. Different concentrations of each compound, including 1, 10, 50, and 100 ppm dissolved in 1% DMSO, were mixed with papa dextrose agar (PDA) medium and poured into Petri dishes. After solidified, mycelial plugs of 5 days old growing colonies of M. roreri were placed at the edge of each Petri dish and incubated at 27 °C for 7 days. The radial growth of M. roreri mycelium was evaluated by measuring the growth on ten points around the radial growth of the colony. Three replicates per treatment were considered (n=30). The growth of M. roreri was also measured from three Petri dishes containing PDA mixed with DMSO as solvent (Xia-Hong 2007).
To verify significant differences between the treatments multiple and paired comparisons analyses were used, including Kruskal-Wallis, Dunn, and Wilcoxon tests for non-parametric data, respectively. Bonferroni-Holm adjusted P values were also considered for reducing the probability of type I and II errors. To determine the lethal dose for each compound (LD50) a probit transformation method, applying a polynomial regression model with an explanation level (R2) greater than 96%, was applied. All statistical tests were performed with a significance level of 95%. The programs R version 3.6.2 and Infostat version 2018 were used.
RESULTS AND DISCUSSION
Two fractions and one pure compound were obtained in our study, namely F2, F3, and C1. The biol F2, obtained by column separation, showed a chromatogram (Figure 1) with 11 peaks of different intensities. Table 1 lists the compounds that were structurally assigned by the database. The proposed structures for this fraction correspond mostly to hydrocarbons.

Figure 1
Analytical gas chromatogram of the F2 fraction (60:40 ethyl acetate/methanol), obtained from the biol elaborated at the El Oro province.

It is observed that the majority of compounds identified in this fraction, with a 30.88% relative abundance (Peak 10), were 1,2-Benzenedicarboxylic acid, diisooctyl ester with a retention time of 15.42 min (NIST 2020). With a relative abundance of 9.64%, docosane was also identified in the hexane extract of propolis (relative abundance 15.5%), this compound has been reported with antimicrobial activity (Arserim Uçar et al. 2020). Minority compounds such as tetratetracontane, dibutyl phthalate hexadecane, 1-iodo, eicosane pentadecane, heptacosane, 1-chloro, hexadecanoic acid, butyl ester, octadecane, hexadecane, 2, 6, 10, 14-tetramethyl were also identified. Literature reports that these compounds have been identified in extracts obtained from medicinal plants and microorganisms by using apolar and polar solvents, hexane and methanol, respectively, then antioxidant (Xinsong et al. 2019; Arserim Uçar et al. 2020 and Aziz et al. 2022) and antimicrobial activity (Arserim Uçar et al. 2020; Akwu et al. 2021; Albratty et al. 2023), was reported. The difference between the methodology used in that case and the one used in the present study is that the methanolic extract was fractionated in an open column with a mixture of half-apolar and polar solvents (ethyl acetate/methanol 60:40).
It is observed that the majority of compounds identified in this fraction, with a 30.88% relative abundance (Peak 10), were 1,2-Benzenedicarboxylic acid, diisooctyl ester with a retention time of 15.42 min (NIST 2020). With a relative abundance of 9.64%, docosane was also identified in the hexane extract of propolis (relative abundance 15.5%), this compound has been reported with antimicrobial activity (Arserim Uçar et al. 2020). Minority compounds such as tetratetracontane, dibutyl phthalate hexadecane, 1-iodo, eicosane pentadecane, heptacosane, 1-chloro, hexadecanoic acid, butyl ester, octadecane, hexadecane, 2, 6, 10, 14-tetramethyl were also identified. Literature reports that these compounds have been identified in extracts obtained from medicinal plants and microorganisms by using apolar and polar solvents, hexane and methanol, respectively, then antioxidant (Xinsong et al. 2019; Arserim Uçar et al. 2020 and Aziz et al. 2022) and antimicrobial activity (Arserim Uçar et al. 2020; Akwu et al. 2021; Albratty et al. 2023), was reported. The difference between the methodology used in that case and the one used in the present study is that the methanolic extract was fractionated in an open column with a mixture of half-apolar and polar solvents (ethyl acetate/methanol 60:40).
Analysis of fraction F3 showed a pasty appearance. Of 5 peaks present in the chromatogram, three esters and two hydrocarbons were identified. The majority of peaks identified corresponded to pentadecanoic acid, 14-methyl-, methyl ester (Figure 2). Another compound with a high percent abundance (14.46%) identified was 1,2-benzenedicarboxylic acid, diisooctyl ester mono (2-ethylhexyl) ester (Table 2).

Figure 2
Analytical gas chromatogram of the F3 fraction (60:40 ethyl acetate/methanol), obtained from the biol elaborated at the Guayas province.

1,2-benzenedicarboxylic acid diisooctyl ester identified in F2 was also identified in F3 with the same retention time of 15.42 minutes, but as a different percentage of relative abundance. The compounds reported in this study have also been referenced by other authors. For instance, the 1,2-benzenedicarboxylic acid diisooctyl ester identified in F2, was the main compound observed in the extract of P. granatum fruits (Basheera et al. 2021). Some compounds identified in F2 and F3 have pharmacological properties that are more than antimicrobial, such as butyl palmitate (hexadecanoic acid, butyl ester), which is reported to be a potential alternative to combat sickle cell anemia (Tshilanda et al. 2015), was reported as a liquid emollient and solvent/diluent in the cosmetic industry, obtained in a solvent-free system (Khan et al. 2018). Krishnan et al. (2014) reported that the compound 1,2-Benzenedicarboxylic acid, mono (2-Ethylhexyl) ester (F3) exhibited cytotoxic activity against HepG2 and MCF-7 cancer cell lines and low toxicity against normal HaCaT and NIH 3T3 cell lines 30. As shown, F2 fraction presented a greater amount of compounds (11) than F3 (5) from biols from El Oro and Guayas provinces, respectively. This could be caused by typical microorganism and the specific agroclimatic conditions of the location where the biol was prepared, impacting on its production (Compant et al. 2019; Saad et al. 2020).
The analysis and interpretation of the 1H NMR and 13C-NMR (Table 3), compared with the literature, indicates the presence of an alditol, specifically the so-called Mannitol (2R, 3R, 4R, 5R-Hexane-1,2,3,4,5,6-hexol) m/z: 182, with the molecular formula C6H14O6 (Chapelle et al. 1991; SDBS 2019).

In the 13C-NMR spectrum, three peaks corresponding to three carbons were observed, which compared to the mass spectrum (M+ of 182), helped to conclude that the molecule shows symmetry. Of the three carbons observed, two of them appear in the DEPT in the normal phase identified as methins C-2.5 and C-3.4, signals consistent with carbons adjacent to hydroxyl groups (HO-CH), their chemical shifts correspond at δ: 71.32 and δ: 69.38 respectively, whose H-2.5 protons appear as a multiple with a chemical shift of δ: 3.40; H-3.4 appears as a triplet at δ: 3.54 with an 8 and 6.8 Hz coupling constant with their respective adjacent hydrogens. The third signal in the 13C-NMR spectrum was identified in DEPT as methylene (C-1.6), with a chemical shift of δ: 63.87, also unprotected, which is why it is concluded that it is bound to one hydroxyl group. In 1H NMR two groups of complex signals consistent with their enantiotopic character were also identified, corresponding to d: 3.38 H-1a, 6a, and d: 3.60 H-1b, 6b.
The spectrum of 1H NMR , 1H COSY (Table 3), shows correlations between protons H-1.6↔-OH-1.6 (δH-1a, b,6a, b: 3.38; 3.60m; δOH-1.6: 4.31t; J= 5.6; 6.4), H-2.5↔OH-2.5 (δH-2.5': 3.40m; δOH-2.5: 4.40d J= 5.4), H-3.4↔OH-3.4 (δH-3.4': 3.54 t, δOH-3.4: 4.13 d J=6.8).
Antifungal evaluation
The antifungal assessment carried out against M. roreri, revealed significant inhibitory activity on the three compounds evaluated; fractions F2, F3, and the pure compound C1 when compared to the control, 7 days after inoculation (Figure 3 and 4).

Figure 3
Comparative analysis of M. roreri mycelial growth on PDA media containing different compounds (C1, F2, and F3) evaluated 7 days after inoculation. Each plot represents the total measures per compound compared to the control (Dunn test). Significance is shown as corrected P values (Holm-correction) for each comparison.
Figure 4
Inhibition of mycelial growth of M. roreri in PDA media with different compounds (C1, F2 and F3) evaluated 7 days after inoculation.
The non-parametric Kruskal-Wallis test confirmed that not all treatments are equal or that there are significant differences between at least one pair of treatments (P-val=3.36×10-22). This was confirmed with the post hoc non-parametric comparisons through Dunn's test with Holm correction which revealed all pairwise comparisons between treatments had statistical differences (P-Val Holm-Corrected <0.05).
The control treatment exhibited superior stability, with minimal dispersion in the observed data (values ranging from 10 to 15), and the highest median of 11 among all four treatments. Compound F3 demonstrated moderate stability (values ranging from 7 to 13), with a slightly lower median of 10 compared to the control. However, there is an evident skewness in the violin plot, indicating data accumulation above the median and greater dispersion below the median. Compounds F2 and C1 display higher levels of dispersion and instability in their results, with lower medians of 7.0 and 8.5, respectively (Figure 3). C1 and fraction F2 presented an inversely proportional effect between concentration and growth showing higher inhibition as concentrations of both products were increased. Conversely, fraction F3 showed a directly proportional effect between concentration and growth. Fraction F2 had a higher inhibitory effect of 44.37% compared to C1 and F3 which had values of 28.63% and 8.34%, respectively (Figure 5). The concentration of 100 ppm from fraction F2 showed the most significant control against M. roreri, (P<0.05) and was also the treatment with more stable results (less variability) compared to F1 compound evaluated at the same concentration (100 ppm). C1 showed LD50 values of 45 ppm and F2 of 32.51 ppm. LD50 values for F3 could not be determined. P<2.2×10-16 was obtained by using the Krustal-Wallis method.

Figure 5
Comparative analysis of M. roreri mycelial growth on PDA media containing different concentrations (1, 10, 50 and 100 ppm) of compounds C1, F2, and F3, evaluated 7 days after inoculation. Each plot represents the total measures per treatment compared to the control (Wilcox test). A general test, following the multiple Kruskal-Wallis method, is also shown in the graph. All tests were run with a significance of 95%. Significance shown on the top of each boxplot is read as follows: (0.0001=****), (0.001=***), (0.01=**), (0.05=*), (ns=1).
It is known that 1,2-benzenedicarboxylic compound reports high antimicrobial activity against gram-positive bacteria such as Bacillus cereus, Bacillus coagulants, Streptococcus spp., and Staphylococcus aureus; gram-negative bacteria: Escherichia coli, Proteus mirabilis, Yersinia spp., and Pseudomonas aeruginosa; and two yeasts: Candida albicans and Candida utilis (Binti et al. 2019). In F3, the compound 1,2-benzenedicarboxylic acid, mono (2-ethylhexyl) ester with a high percentage of abundance was also present, for which the literature reports having high efficacy in the control of plant diseases with a similar activity like that of a compound identified from a crude extract of ethyl acetate from a strain of Trichoderma (Xu et al. 2018) This compound was also present in F2, probably responsible for the main affect against the growth of M. roreri. Studies carried out by Ali et al. (2017) report that this compound was the main obtained (58.56%) in a methanolic extract from the roots of Chenopodium album, which also showed high antifungal activity against Sclerotium rolfsii. There were compounds with antibacterial activity, such as eicosane; 1,2 benzenedicarboxylic acid; and diisocityl ester acid. Eicosane, has been identified in macroalgae (Troncoso et al. 2015) and acid, diisooctyl ester (5.17%) in ethanolic extract of Phoenix pusilla fruit (Thangadurai and Velavan, 2018). Other compounds with antifungal activity, such as heptacosane, 1-chloro (7.04% relative abundance), have also been found in ethyl acetate extracts of aerial parts of Quisqualis indica (Akriti et al. 2017). The hexadecanoic acid butyl ester was reported in the alcoholic extract of Chenopoidium (Ali et al. 2017 and El-Shahir et al. 2022), which differs from what we reported in this study, ethyl acetate/methanol 60:40.
From the compound isolated from the ethyl acetate fraction of biol (C1) from the province of El Oro. After the isolated we obtained a white solid pellet (60 mg) with a 164 °C melting point, soluble in methanol. The compound C1, identified by NMR in this study as mannitol, has also been isolated from the olive leaves (Lama-Muñoz et al. 2020). The activity of mannitol has been characterized as bacteriostatic (Fernández-Bolaños et al. 2000) against positive bacteria including Bacillus circulans, Enterococcus avium, Enterococcus avium Proteus vulgaris Bacillus circulans Enterobacter gregoviae, Enterococcus asacchrolyticus, and Bacillus brevis (Singh, 2014). Other studies show the role of mannitol in increasing the sensitivity of persistent bacteria forming biofilms (Pseudomonas aeruginosa) to antibiotics (Barraud et al. 2013), advising it as an attractive raw material for developing next-generation antibiotics (Nguyen et al. 2019). It could be inferred from our results that the biological activity found in the liquid organic amendments of this research, including its effect on reducing the growth of M. roreri, could be to the presence of antifungal compounds including 1,2-benzene carboxylic acid, bis (2-methyl propyl) ester, acid 1,2-benzenedicarboxylic acid, mono (2-Ethylhexyl) ester and mannitol. Further research is needed to assess if these compounds have synergistic interactions with other compounds also present in these products.
CONCLUSIONS
The biological activity observed in some liquid organic amendments (Biols), as the ones studied in this work obtained by anaerobic fermentation, can be related to the presence of secondary metabolites and hydrocarbons with antifungal properties. The high abundance (30.88%) of 1,2-Benzenedicarboxylic acid, diisooctyl ester and the rest of the compounds identified in fraction F2 could be related to the higher inhibitory activity against Moniliophthora roreri. The use of GC-MS and NMR can be used to identify compounds with high accuracy for further characterization and serve the purpose of molecule discovery for new applications, either in agriculture or related fields. This report presents a novel method of improving bioles to promote multiple crop growth, using a natural fermentation process that produces bioactive compounds capable of inhibiting the growth of M. roreri. Notably, the process avoids synthetic chemical products, facilitating organic waste management and promoting green chemistry. Moreover, in this study the biol production process could serve as a potential natural bioreactor for developing other bioactive components, such as antioxidants and antimicrobials, for future applications in the cosmetic, food, and pharmaceutical industries. However, further research is necessary to explore these exciting possibilities fully.
ACKNOWLEDGMENTS
The authors thank the Escuela Superior Politécnica del Litoral (ESPOL) for providing the financial support for this research.
REFERENCES
Ali A, Javaid A and Shoaib A (2017) GC-MS Analysis and antifungal activity of methanolic root extract ofChenopodium albumagainstSclerotium rolfsii. Planta Daninh 35:1-8. https://doi.org/10.1590/S0100-83582017350100046
Akriti A, Rajmani P, Sayed K, Lalitesh K (2017) GC-MS analysis and antibacterial activity of plant extracts. Indian Journal of Pharmaceutical Education and Research 51(2):329-336. https://doi.org/10.5530/ijper.51.2.39
Akwu NA, Naidoo Y, Channangihalli ST et al (2021) The essential oils of Grewia Lasiocarpa E. Mey. Ex Harv.: chemical composition, in vitro biological activity, and cytotoxic effect on Hela cells. Anais Da Academia Brasileira De Ciências 93(2). https://doi.org/10.1590/0001-3765202120190343
Albratty M, Alhazmi HA, Meraya AM et al (2023) Spectral analysis and Antibacterial activity of the bioactive principles of Sargassum tenerrimum J. Agardh collected from the Red sea, Jazan, Kingdom of Saudi Arabia. Brazilian Journal of Biology 83. https://doi.org/10.1590/1519-6984.249536
Anzules-Toala V, Pazmiño-Bonilla E, Alvarado-Huamán L et al (2021) Control of cacao (Theobroma cacao) diseases in Santo Domingo de los Tsáchilas, Ecuador. Agronomía Mesoamericana 33(1). https://doi.org/10.15517/am.v33i1.45939
Arserim Uçar DK, Geçibesler İH, Sudağıdan M et al (2020) Bingöl Propolis İzolatlarının Biyolojik Aktivitesinin, Lipofilik ve Uçucu Organik Bileşenlerinin Belierlenmesi . Türk Doğa ve Fen Dergisi 9: 92-102. https://doi.org/10.46810/tdfd.776424
Aziz M, Ahmad S, Khurshid U et al. (2022) Comprehensive biological potential, phytochemical profiling using GC-MS and LC-ESI-MS, and in-silico assessment of Strobilanthes glutinosus Nees: An Important Medicinal Plant. Molecules 27(20):6885. https://doi.org/10.3390/molecules27206885
Barraud N, Buson A, Jarolimek W and Rice S (2013) A mannitol enhances antibiotic sensitivity of persister bacteria in Pseudomonas aeruginosa Biofilms. PLoS One 8 (12). https://doi.org/10.1371/journal.pone.0084220
Bernal R (2010) Enfermedades de tomate (Lycopersicum esculentum Mill) en invernadero en las zonas de Salto y Bella Unión, INIA Serie Técnica 181, Montevideo. 1-71. https://n9.cl/pr2lx
Basheera S, Sivanandan S and Kamalan BC (2021) Anti-tuberculosis activity in Punica granatum: In silico validation and identification of lead molecules. Indian Journal of Pharmaceutical Sciences 83(2):316-330. https://doi.org/10.36468/pharmaceutical-sciences.778
Binti N, Sahadan Y, Rozman NS et al (2019) Development of medical cotton fabrics with Punica granatum L extract finishing for nosocomial infections control. Journal of Natural Fibers 16(3): 404-411. https://doi.org/10.1080/15440478.2017.1423260
Chapelle S and Verchere J (1991) A 13C-n.m.r. Study of the tungstate and molybdate complexes of perseitol, galactitol, and D-mannitol. Carbohydrate Research 211(2):279-286. https://doi.org/10.1016/0008-6215(91)80097-7
Chóez-Guaranda I, Viteri-Espinoza R, Barragán-Lucas A, Quijano-Avilés M, Manzano P (2022) Effect of solvent-solvent partition on antioxidant activity and GC-MS profile of Ilex guayusa Loes. leaves extract and fractions. Natural Product Research 36(6):1570-1574. https://doi.org/10.1080/14786419.2021.1882455
Compant S, Samad A, Faist H and Sessitsch A (2019) A review on the plant microbiome: Ecology, functions, and emerging trends in microbial application. Journal of Advanced Research 19: 29-37. https://doi.org/10.1016/j.jare.2019.03.004
El-Shahir A, El-Wakil D, Abdel A and Youssef N (2022) Bioactive compounds and antifungal activity of leaves and fruits methanolic extracts ofZiziphus spina-christiL. Plants 11(6):746. https://doi.org/10.3390/plants11060746
Enríquez G (2010) Cacao orgánico guía para productores ecuatorianos (2a ed.). En: Repositorio Digital INIAP, En: Repositorio Digital INIAP, http://repositorio.iniap.gob.ec/handle/41000/4571. 202 p.; consultado: accessed: November 2020.
Fernández-Bolaños J, Heredia A, Felizón B, Guillén R, Jiménez A y Rodríguez R (2000) Procedimiento de obtención de manitol a partir de pulpa extractada de aceitunas. Patente de España n.° 2143939. Retrieved from: http://hdl.handle.net/10481/2854
Goyes-Campos S y Monserrate-Gómez P (2017) El impacto de los abonos orgánicos en la agricultura importancia para el estudiante de agronomía. Opuntia Brava 9(2):104-111. https://n9.cl/8ba0c
Hidalgo P, Sindoni M and Marín C (2009) Evaluación de sustratos a base de vermicompost y enmiendas orgánicas líquidas en la propagación de parchita (Passiflora edulis v. flavicarpa) en vivero. Revista Científica UDO Agrícola 9(1):126-135. https://dialnet.unirioja.es/servlet/articulo?codigo=3293844
Jaramillo-Rodríguez M (2015) Aplicación de enmiendas orgánicas y biochars derivados de la industria oleícola en el cultivo del arroz: influencia en la dinámica de plaguicidas y en propiedades agronómicas. (Tesis Doctoral). Universidad de Sevilla. Sevilla, España.
Jiménez M (2008) Effect of the nutritional status of banana (Musa spp) on leaf disease infestation by Mycosphaerella fijiensis Morelet in Ecuador. (Doctoral thesis). Katholieke Universiteit Leuven. Belgium. 83 p.
Khan N, Gawas S, Rathod V (2018) Enzyme-catalysed production of n-butyl palmitate using ultrasound-assisted esterification of palmitic acid in a solvent-free system. Bioprocess Biosystems Engineering 41(11):1621-1634. https://doi.org/10.1007/s00449-018-1988-y
Krishnan K, Mani A and Jasmine S (2014) Cytotoxic activity of bioactive compound 1, 2-benzene dicarboxylic acid, mono 2-ethylhexmarine-derivedcted from a marine derived Streptomyces sp VITSJK8. International Journal of Molecular and Cellular Medicine 3(4):246-254. https://www.ncbi.nlm.nih.gov/pmc/articles/PMC4293612/
Lama-Muñoz A, Contreras M, Espínola F et al (2020) Content of phenolic compounds and mannitol in olive leaves extracts from six Spanish cultivars: Extraction with the Soxhlet method and pressurized liquids. Food Chemistry 320. https://doi.org/10.1016/j.foodchem.2020.126626
León-Aguilar R, Peñarrieta-Bravo S, Torres-García A et al (2016) Efecto de la materia orgánica y microorganismos eficientes en el comportamiento productivo de la acelga. Revista Espamciencia 7(2):127-133.
Magdama-Tobar F (2016) Estudio del efecto de bioles y cepas de Trichoderma sp aisladas de zonas cacaoteras, como alternativas de control de Moniliophthora roreri en Condiciones in vitro. (Tesis de Licenciatura). Escuela Superior Politécnica del Litoral. Guayaquil, Ecuador. 55 p.
Manzano P, Baquerizo M y Viteri R (2010) Determinación de saponina total y alcaloides en enmiendas orgánicas líquidas (Bioles). Págs. 586. En: Libro de memorias de la XIX Reunión internacional ACORBAT, Colombia.
Melero-Vara J, Borrego-Benjumea A, Vela-Delgado M et al (2017) La aplicación de enmiendas orgánicas al suelo en el manejo de las fusariosis del clavel, espárrago y tomate. Control Biológico de Enfermedades Vegetales 16:129-134.
Montes-de-Oca-Marquez C, Hernandez-Delgado C, Orozco-Martínez J et al (2017) Antibacterial and antifungal activity of Dalea carthagenensis (JACQ) J.F. MACBR. Revista Fitotecnia Mexicana 40(2):161-168. https://www.redalyc.org/pdf/610/61051413008.pdf
Nguyen T, Kim T, Ta H et al (2019) Targeting mannitol metabolism as an alternative antimicrobial strategy based on the structure-function study of mannitol-1-phosphate dehydrogenase in Staphylococcus aureus. MBio, 10 (4):1-23. https://doi.org/10.1128/mBio.02660-18
NIST - National Institute of Standards and Technology. 1,2-Benzenedicarboxylic acid, diisooctyl ester. https://doi.org/10.18434/T4D303
Orellana T, Manzano P, Chávez E et al (2013) Estándares de fermentación y maduración artesanal de bioles. Yachana Revista Científica 2(1):1-7. https://doi.org/10.1234/ych.v2i1.186
Quiroga L, Bolaños M y Bravo E (2013) Efecto de la aplicación de fungicidas y bagazo de caña sobre la actividad biológica de la rizósfera de aguacate (Persea americana Mill). (Master's Thesis). Universidad del Valle. Cali, Colombia. 5 p.
Revilla-Cervantes P y Palomo-Herrera A (2016) Comportamiento con diferentes enmiendas orgánicas del nematodo del nódulo Meloidogyne incognita (Kofoid and White, 1919), Chitwood1949, en Pimiento Paprika (Capsicum annum L.). Anales Científicos 77 (2): 212-217. http://dx.doi.org/10.21704/ac.v77i2.490
Saad MM, Eida AA and Hirt H (2020) Tailoring plant-associated microbial inoculants in agriculture: a roadmap for successful application. Journal of Experimental Botany 71(13):3878-3901. https://doi.org/10.1093/jxb/eraa111
SDBS -Spectral Database for Organic Compounds (2019) In: SDBSWeb National Institute of Advanced Industrial Science and Technology, SDBS -Spectral Database for Organic Compounds (2019) In: SDBSWeb National Institute of Advanced Industrial Science and Technology, https://sdbs.db.aist.go.jp; accessed: April 2020.
Serrano P (2017) La Biodesinfección Como Técnica de Control de Phytophthora nicotianae En El cultivo de pimiento. (Tesis Doctoral). Universidad de Extremadura. Badajoz. España. 216 p.
Singh B R (2014) Antibacterial activity of glycerol, lactose, maltose, mannitol, raffinose and xylose. Noto-are: 1-3.
Varo-Suárez Á (2017) Evaluación de enmiendas orgánicas, microorganismos y productos naturales para el control biológico de la verticilosis en olivo. (Tesis Doctoral). Universidad de Córdoba. Córdoba, Argentina.
Thangadurai T and Velavan S (2018) Bioactive compound in ethanolic extract of Phoenix pusilla fruit using GC-MS Technique. Journal of Biological and Chemical Research 35(2): 778-784.
Troncoso N, Saavedra R, Olivares A et al (2015) Identificación de compuestos antibacterianos en macroalgas presentes en la región del Biobío, Chile. Revista de biología marina y oceanografía 50(1): 199-204. http://dx.doi.org/10.4067/S0718-19572015000200007
Tshilanda D, Ngbolua K, Tshibangu D et al (2015) Synthesis and in vitro antisickling activity of some non-aromatic esters. Chemical Science International Journal 11(3):1-5 https://doi.org/10.9734/ACSJ/2016/22734
Uribe-Lorio L, Castro-Barquero L, Arauz-Cavallini F, Henríquez-Henríquez C and Blanco-Meneses M (2014) Pudrición basal causada por Phytophthora capsici en plantas de chile tratadas con vermicompost. Agronomía Mesoamericana 25(2):243-253.
Xia-Hong H (2007) Bio-control of root rot disease in vanilla. (Tesis Doctoral), University of Wolverhampton. Wolverhampton, Reino Unido.
Xinsong S, Ting Y, Lu D et al (2019) Identification and analysis of secondary metabolites from CH3OH/H2O Extract of Metacordyceps neogunnii. E3S Web of Conferences 118. https://doi.org/10.1051/e3sconf/201911801027
Xu B, Gan Y, Zhang S, and Zhang J (2018) Identification of the antifungal activity of Trichoderma longibrachiatum T6 and assessment of bioactive substances in controlling phytopathgens. Pesticide Biochemistry and Physiology 147:59-66. https://doi.org/10.1016/j.pestbp.2018.02.006
